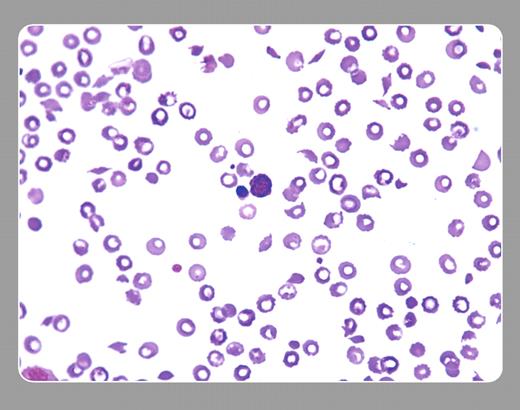
Neil Abramson, Baptist Cancer Institute. / A 57-year-old woman with breast cancer refractory to several combinations of chemotherapy was placed on a regimen that included mitomycin. She showed objective improvement. After 3 months of therapy, thrombocytopenia, anemia, and azotemia developed. The peripheral smear, seen above, shows numerous schistocytes, moderate thrombocytopenia, and a nucleated red cell. Many red cells have well-demarcated centers that represent artefacts. Coagulation tests were normal. Chemotherapy was withheld, and plasma exchange afforded marginal benefit. She died months later with extensive metastatic disease and pathologic evidence of microvascular thrombotic disease. / The peripheral smear affirmed the clinical picture of thrombotic thrombocytopenic purpura (TTP). Mitomycin was one of the first drugs causally related to TTP. Several other drugs (clopidogrel, ticlopidine, cyclosporine, et cetera), including several other chemotherapy agents, especially when used with autologous and allogeneic marrow transplantation, can result in the same peripheral smear. / TTP may be a final common pathway of several different processes, some of which include immunologic diseases, infectious processes, and malignancy (by itself or associated with its treatment). Most cases of TTP show congenital or acquired deficiencies or dysfunction of the ADAMTS 13 protease. With the patient noted above, the measurement of this protease was unavailable.

Neil Abramson, Baptist Cancer Institute
A 57-year-old woman with breast cancer refractory to several combinations of chemotherapy was placed on a regimen that included mitomycin. She showed objective improvement. After 3 months of therapy, thrombocytopenia, anemia, and azotemia developed. The peripheral smear, seen above, shows numerous schistocytes, moderate thrombocytopenia, and a nucleated red cell. Many red cells have well-demarcated centers that represent artefacts. Coagulation tests were normal. Chemotherapy was withheld, and plasma exchange afforded marginal benefit. She died months later with extensive metastatic disease and pathologic evidence of microvascular thrombotic disease.
The peripheral smear affirmed the clinical picture of thrombotic thrombocytopenic purpura (TTP). Mitomycin was one of the first drugs causally related to TTP. Several other drugs (clopidogrel, ticlopidine, cyclosporine, et cetera), including several other chemotherapy agents, especially when used with autologous and allogeneic marrow transplantation, can result in the same peripheral smear.
TTP may be a final common pathway of several different processes, some of which include immunologic diseases, infectious processes, and malignancy (by itself or associated with its treatment). Most cases of TTP show congenital or acquired deficiencies or dysfunction of the ADAMTS 13 protease. With the patient noted above, the measurement of this protease was unavailable.
Neil Abramson, Baptist Cancer Institute
A 57-year-old woman with breast cancer refractory to several combinations of chemotherapy was placed on a regimen that included mitomycin. She showed objective improvement. After 3 months of therapy, thrombocytopenia, anemia, and azotemia developed. The peripheral smear, seen above, shows numerous schistocytes, moderate thrombocytopenia, and a nucleated red cell. Many red cells have well-demarcated centers that represent artefacts. Coagulation tests were normal. Chemotherapy was withheld, and plasma exchange afforded marginal benefit. She died months later with extensive metastatic disease and pathologic evidence of microvascular thrombotic disease.
The peripheral smear affirmed the clinical picture of thrombotic thrombocytopenic purpura (TTP). Mitomycin was one of the first drugs causally related to TTP. Several other drugs (clopidogrel, ticlopidine, cyclosporine, et cetera), including several other chemotherapy agents, especially when used with autologous and allogeneic marrow transplantation, can result in the same peripheral smear.
TTP may be a final common pathway of several different processes, some of which include immunologic diseases, infectious processes, and malignancy (by itself or associated with its treatment). Most cases of TTP show congenital or acquired deficiencies or dysfunction of the ADAMTS 13 protease. With the patient noted above, the measurement of this protease was unavailable.
Many Blood Work images are provided by the ASH IMAGE BANK, a reference and teaching tool that is continually updated with new atlas images and images of case studies. For more information or to contribute to the Image Bank, visit www.ashimagebank.org.